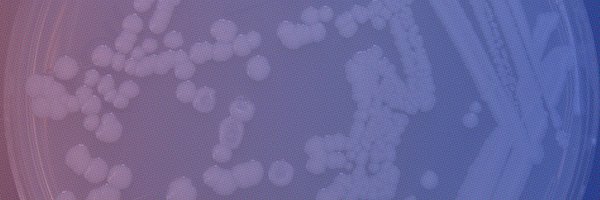
UF_MCS Profile Banner

UF Microbiology
@UF_MCS
Followers
1K
Following
402
Media
60
Statuses
618
big ideas come in small packages 🔬🦠🧫 a University of Florida/IFAS department
Gainesville, FL
Joined August 2011
.@UF_MCS’s Dr. Xin Wang has engineered E. coli with a redesigned electron transport chain, boosting ATP by 56%. This next-gen chassis supports efficient, large-scale production of energy-intensive compounds. License this @UF tech today! 🔗: https://t.co/SFv7F42pdb
1
1
2
.@UF_MCS scientists working with our Crop Transformation Center have developed a plant they're calling NuCitrus that tolerates disease attacks and produces high-quality fruit despite high HLB pressure in field trials. More on this exciting development for the citrus industry:
0
3
6
One of this year’s #InventionoftheYear awards goes to @UF_MCS’ Dr. Raquel Dias and her team for developing an Integrative Framework for Predicting JAK Mutations and Their Impact on Drug Efficacy. Congratulations on advancing more effective, personalized therapies! #SI2025
0
1
2
Flesh-eating bacteria. Brain-colonizing fungus. Brain-eating amoeba. Haunted horned rabbit virus. Parasitic zombie fungus. Swiss-cheese brain disease. 🧟🐰🧠🧀 You don’t need a haunted house, just a microscope. Meet the microbes that keep us up at night: https://t.co/3I5EZzLKNI.
0
5
7
MCS Alumni and UF Health Shands Hospital clinical coordinator, Jhoan Moncada, discusses how clinical microbiology has changed and why there is a greater demand for trained clinical laboratory microbiologists than ever. To learn how to apply, click here: https://t.co/OqwSuzZdVP
0
1
1
.@UF_MCS-developed classroom lessons are helping high school students understand the dangers associated with antimicrobial resistance ➡️ https://t.co/WL57iWG0t3
0
3
9
@Gatorade @UF @UFMedicine @UFHealth @UFHealthCancer @NASA @UF_CLAS @UFAstraeus @kerihoadley Researchers like Nils Averesch are engineering microbes at UF's Space Life Science Lab to create sustainable solutions for space missions and environmental challenges.
1
1
9
End of an era. Wait, like it’s 1993 to see what our website looked like in the dial-up days 💾
0
2
3
Loss of cannabinoid receptors weakens immune defenses against #Salmonella. This #mBio study shows how CB1R and CB2R differently shape infection outcomes and #microbiota. https://t.co/GD52Ns2xek
@UF_IFAS @UF_MCS @mjedelmann #CannabinoidScience #Immunology
0
5
7
Great having you on the team this summer, Ryan Cantrell & best wishes ahead at @UF_MCS. Thanks to @edi_diazb for his guidance & support in the lab @UFIFAS_IRREC @UFPlantPath, @UFCALS for supporting this work through the Summer Internship Fellowship & @USDA_NIFA,
0
3
14
As antibiotic resistance grows, @UF_MCS scientists may have found a new way to fight back. Their latest research reveals a compound that, when paired with antibiotics, nearly wiped out a major foodborne pathogen — and even showed promise against drug-resistant “superbugs.”
2
4
5
Meet Dr. José Rolando, assistant professor of @UF_MCS at @UFIFAS_FLREC More on Dr. Rolando’s vision — forging paths toward smarter, more sustainable futures for Florida’s farms and ecosystems 🔗 https://t.co/CvetoQMv2p
0
4
5
Scientists discovered three new truffle species — including one worth hundreds per pound. 🍄🟫 @UF_MCS researchers uncovered surprises beneath the soil that are changing what we know about gourmet fungi, forest ecosystems, and even truffle cultivation. More on the discoveries
1
4
21
Dr. Maupin-Furlow & Dr. @Huiyong_Jia from @UF_MCS created a powerful nuclease complex using extremophile enzymes. It breaks down RNA and ssDNA, streamlining genetic cleanup and improving RNA quality control in research and biotech. 🧬 License this tech🔗: https://t.co/HfkAlNU4Xj
1
1
3
.@UF_MCS researchers developed a gut-targeted therapy using bacteriophages to eliminate harmful bacteria linked to toxic protein buildup in neurodegenerative diseases like Alzheimer’s—paving the way for precise, microbiome-based treatments. 🔗: https://t.co/31ewMbBbbv
1
1
2
We're excited to announce @UF_MCS Dr. Monika Oli and @UF_FSHN Dr. Soohyoun Ahn as the 2025 winners of the Innovation in Teaching & Learning with Navigator AI Award: https://t.co/n9KZe9ud65. 🐊
0
1
6
How can a one-millimeter worm help understand how bacteria affect neurodegenerative diseases like Alzheimer's? Watch the full video to learn how the @360Science Lab from @UF_MCS uses C. elegans to examine how bacteria influence protein stability! 📹🔗: https://t.co/iCgH6r4pUc.
0
6
8
.@UF_MCS researchers have developed a probiotic that may help prevent autism and other neurodevelopmental disorders in at-risk children by restoring beneficial gut bacteria. A game-changer for early intervention! #Neurodevelopment #Probiotics #ASD🦠 ➡️: https://t.co/8VqjrSLed5
1
1
1
Great Fern lab representation at #fps2025 @FPSFloridaPhyt1 @UFCALS @UF_IFAS @UF_MCS Huge congrats to @micro_rach on winning first place for oral presentation! So proud! 💓👏
0
4
16